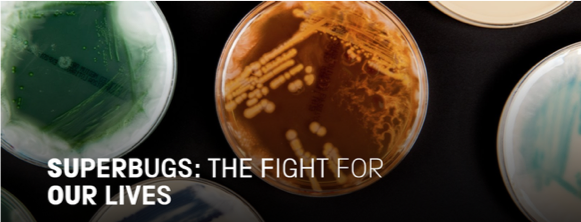

Antimicrobial (or antibiotic) stewardship (AMS) is a key component of a multifaceted approach to slowing the emergence of antimicrobial resistance (AMR). Antimicrobial stewardship programmes (ASPs) are designed to ensure that patients receive the right antibiotic at the right dose and for the right duration. This strengthens infection prevention and control while minimising adverse events and unnecessary use of antibiotics. The main goals of ASPs are to improve patient outcomes, increase patient safety, reduce the emergence of resistance and optimise healthcare costs.
The core mission of the pharmaceutical industry is to bring innovative therapies to patients that significantly improve their lives. At the same time, we are addressing AMR through a comprehensive approach, partnering with stakeholders on several initiative and actions. It is in everybody’s interest to keep existing antibiotics working and ensure new treatments are effective against resistant bacteria.
From a Pfizer’s perspective, we have made significant investments in infectious disease research and development, including preventive vaccines. Additionally, we promote stewardship through a variety of channels including: education and training for healthcare professionals (HCPs), public awareness-raising initiatives both online and offline, supporting local stewardship development through unrestricted grants, partnering with hospitals and governments to make their resistance data available to their physicians, and collecting and providing resistance information in areas where it is otherwise unavailable.
Partnerships on Education and Awareness-Raising